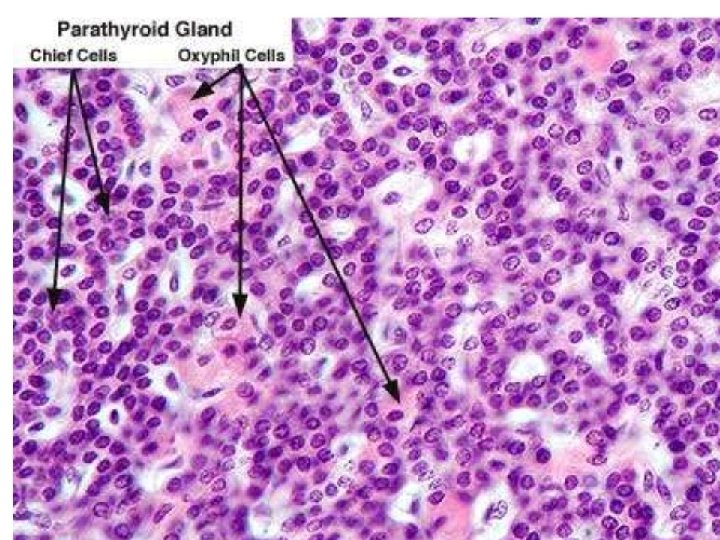

Histology of the thyroid Dr Ahmed Abdulhussein ALHuchami

Histology of the thyroid Dr. Ahmed Abdulhussein AL-Huchami


Location of thyroid gland US Federal Government, wikimedia commons



Thyroid follicle Modified from Hedge 1987


Thyroid gland Thyroid follicles – Thyroid hormones: thyroxine (T 4), triiodothyronine (T 3). – General function: To increase the body's metabolic rate. – Main control: Pituitary TSH. Parafollicular cells (= C-cells) – Hormone: Calcitonin. – General function: Lower serum calcium. – Main control: Serum calcium level.


Thyroid follicles, LM Stan Erlandsen Medical Histology slide collection, slide MH 9/D/6

Thyroid follicles, LM Hadley Kirkman (Stanford) slide collection, slide K 27

Production of thyroid hormones by a follicular cell Synthesize thyroglobulin and then secrete it into the colloid. Iodinate tyrosine residues on thyroglobulin. When stimulated by pituitary TSH, take up the thyroglobulin and break it down in lysosomes to release thyroid hormones T 3 and T 4. Colloid Modified from Junqueira and Carneiro, 10 th ed. , 2003, page 426, fig. 21 -19 by R. Mortensen

Functional. Normal states of thyroid follicles Normal Underactive = hypoactive Overactive = hyperactive


Underactive (hypoactive) thyroid follicles, LM A. K. Christensen

Overactive (hyperactive) thyroid follicles Medical Histology atlas by Stanley L. Erlandsen and Jean E. Magney


Thyroid gland Parafollicular cells (= C-cells) – Hormone: Calcitonin. – General function: Lowers serum calcium. – Main control: Serum calcium level.

C cell location in thyroid Hedge 1987


C-cell in thyroid follicular epithelium, LM C-cell A. K. Christensen


Parathyroid gland



Parathyroid gland Chief (or principal) cells – Hormone: Parathyroid hormone (PTH). – Main function: Raises serum calcium, lowers serum phosphate. – Main control: Serum calcium level. Oxyphil cells – Occasional cells or small clusters. – Function unknown. – Name means "acid [stain] loving" (Greek).



Parathyroid gland (mostly chief cells) , low power LM Blood vessel Humio Mizoguti, Kobe Univ Sch Med, slide 542

Parathyroid, chief cells, one oxyphil (arrow), LM Fat cell Humio Mizoguti, Kobe Univ Sch Med

Oxyphil cell cluster, LM Fat cell A. K. Christensen

Regulation of serum calcium Parathyroid hormone (from parathyroid) Ca++ ↑ Calcitonin (thyroid parafollicular cells) Ca++¯

THANK YOU
- Slides: 35